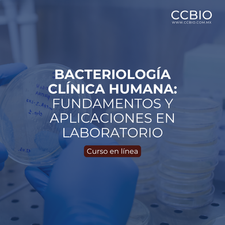

Cursos por iniciar
Nuestras áreas
Alimentos
Programas enfocados en optimizar procesos de manufactura y cumplimiento de estándares sanitarios para el sector alimentario.
Biociencias y biotecnología
Programas orientados al dominio de herramientas biotecnológicas modernas para la creación y mejora de sistemas biológicos complejos.
Biología molecular y genómica
Programas enfocados en la manipulación precisa de ácidos nucleicos y el uso de bioinformática para el análisis de genomas complejos.
Ciencias forenses
Programas orientados al correcto manejo de pruebas biológicas y la elaboración de dictámenes periciales oficiales.
Clínica y microbiología
Programas diseñados para perfeccionar el manejo de muestras biológicas y la emisión de resultados dentro de los laboratorios.

Económico y administrativo
Programas enfocados en el análisis de rentabilidad, planeación y optimización de recursos económicos en instituciones.
Farmacéuticas y analíticas
Programas diseñados para optimizar procesos de control de calidad y la interpretación de marcos regulatorios vigentes.
Formación científica
Programas enfocados en la metodología de la investigación, diseño de protocolos y cumplimiento de estándares editoriales científicos.
Fisicoquímica y matemáticas
Programas diseñados para el dominio de cálculos críticos y la interpretación estadística de datos científicos en procesos experimentales.
Gestión y normatividad de laboratorio
Programas diseñados para la optimización de procesos operativos bajo un enfoque de mejora continua.
Cursos semipresenciales / presenciales
Nuestra
Esencia
¡Inspirar para crear, crecer y aprender continuamente!
Ofrecemos servicios de consultoría, capacitación y asesorías en el área de la salud, empresas, instituciones públicas, universidades, profesionales y al público en general.
Capacitadores
60+
Alumnos
20,000+
Estudiando ahora
2,000+
Cursos
180+
¡Experiencia que nos respalda!
Contáctanos


¡Informes, inscripciones empresariales y servicios especiales!
¿Tienes alguna duda, necesitas una cotización grupal o un formato de certificado personalizado? Nuestro equipo de asesores está listo para ayudarte a gestionar tu inscripción con atención directa.
.png)